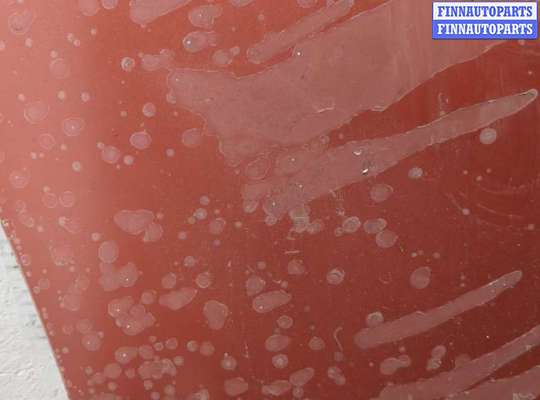
купить Капот на Mitsubishi Outlander XL 2006-2012

Капот для Peugeot 4007
с бесплатной доставкой в Ярославль, Рыбинск
Купить капот на Peugeot 4007 (Пежо 4007) в Ярославле, Рыбинске:
Товар в наличии по состоянию на 16.02.2026 14:18:
отсортировать товар по
Капот
2009; Бензин; 2.4; 4B12, Инжектор; Джип (5 дв.); ; черный; 2009, 2.4л, Бензин, Инжектор, 4B12, 5900A112, Джип (5-дверный), черный, ржавчина, глубокие царапины, вмятины, царапины, вмятины, дефект покрытия (ЛКП), порвана обшивка,, ржавчина, глубокие царапины, вмятины, царапины, вмятины, дефект покрытия (ЛКП), порвана обшивка
OEM: 5900A112
OEM: 5900A112
Капот
2009; Дизель; 2.0; BSY, Турбо; Джип (5 дв.); ; красный; 2009, 2л, Дизель, Турбо, BSY, 5900A112, Джип (5-дверный), красный, вмятины, ржавчина, царапины, дефект покрытия (ЛКП), порвана обшивка,, вмятины, ржавчина, царапины, дефект покрытия (ЛКП), порвана обшивка
OEM: 5900A112
OEM: 5900A112
Капот
2010; Дизель; 2.2; 4HN, Турбо; Джип (5 дв.); ; серебристый; 2010, 2.2л, Дизель, Турбо, 4HN, 5900A112, Джип (5-дверный), серебристый, царапины, вмятины,, царапины, вмятины
OEM: 5900A112
OEM: 5900A112
Капот
2011; Дизель; 2.3; 4N14, Турбо; Джип (5 дв.); ; красный; 2011, 2.3л, Дизель, Турбо, 4N14, Джип (5-дверный), красный, Фото не актуально, с запчасти отделены: Обшивка капота, царапины, загнут угол (кромка),, царапины, загнут угол (кромка)
| Фото | Артикул | Запчасть | Автомобиль | Параметры | |
|---|---|---|---|---|---|
| Капот | Mitsubishi Outlander XL II 2007 - 2009 |
2009; Бензин; 2.4; i; Джип (5 дв.); ; Полный; Вмятины, царапины
|
|
||
| Капот | Mitsubishi Outlander XL 2006-2012 |
2009; Бензин; 2.4; 4B12, Инжектор; Джип (5 дв.); ; черный; 2009, 2.4л, Бензин, Инжектор, 4B12, 5900A112, Джип (5-дверный), черный, ржавчина, глубокие царапины, вмятины, царапины, вмятины, дефект покрытия (ЛКП), порвана обшивка,, ржавчина, глубокие царапины, вмятины, царапины, вмятины, дефект покрытия (ЛКП), порвана обшивка
OEM:
5900A112
|
|
||
| Капот | Mitsubishi Outlander XL 2006-2012 |
2009; Дизель; 2.0; BSY, Турбо; Джип (5 дв.); ; красный; 2009, 2л, Дизель, Турбо, BSY, 5900A112, Джип (5-дверный), красный, вмятины, ржавчина, царапины, дефект покрытия (ЛКП), порвана обшивка,, вмятины, ржавчина, царапины, дефект покрытия (ЛКП), порвана обшивка
OEM:
5900A112
|
|
||
| Капот | Mitsubishi Outlander XL 2006-2012 |
2010; Дизель; 2.2; 4HN, Турбо; Джип (5 дв.); ; серебристый; 2010, 2.2л, Дизель, Турбо, 4HN, 5900A112, Джип (5-дверный), серебристый, царапины, вмятины,, царапины, вмятины
OEM:
5900A112
|
|
||
| Капот | Mitsubishi Outlander XL 2006-2012 |
2011; Дизель; 2.3; 4N14, Турбо; Джип (5 дв.); ; красный; 2011, 2.3л, Дизель, Турбо, 4N14, Джип (5-дверный), красный, Фото не актуально, с запчасти отделены: Обшивка капота, царапины, загнут угол (кромка),, царапины, загнут угол (кромка)
|
|
||
| капот | CITROEN C-CROSSER |
2008; Дизель; 4HN (DW12MTED4); Джип (5 дв.); ; вмятины
|
|
||
Технические характеристики капота:
Тех. характеристики:
| Выпуск: | 2007–2012 |
| Тип топлива: | Бензин, Дизель |
| Объём ДВС, л: | 2.0, 2.2, 2.3, 2.4 л |
| Тип кузова: | Джип (5 дв.) |
| OEM-номера: | 5900A112 |
Цена: 18160 руб.
от 6490 до 33590 руб.
Цена зависит от состояния и комплектации детали.
ОСТАВИТЬ ЗАПРОС
также вы можете посмотреть другие детали на Peugeot 4007
Ищете капот?
Подберём и доставим запчасти для а/м 4007
в Ярославль, Рыбинск
в Ярославль, Рыбинск
Доставка от 2 до 6 дней
Наложенный платеж. Оплата при получении.
Большой ассортимент
более 400 000 запчастей
Лидеры на рынке
крупнейшая компания
Высококлассные специалисты
профессиональный подход
Ответственность
перед клиентами
Бесплатная доставка
в 242 города России (подробнее)
Гарантия на детали
30 дней на ДВС, 14 на остальное
Мы работаем уже 5 лет на рынке запчастей Peugeot, и нашими клиентами стали тысячи довольных покупателей.
На нашей разборке Peugeot в Санкт-Петербурге и Ярославле, Рыбинске работают только профессионалы.
Если вам нужны оригинальные запчасти на а/м Peugeot 4007 хорошего качества по невысокой цене, ваш выбор — FINNAUTOPARTS.
Мы разбираем автомобили Peugeot 4007, не имеющие пробега по РФ.
У нас очень широкий ассортимент запчастей, включая контрактные двигатели (ДВС),
пункт выдачи заказов в Ярославле, Рыбинске.
А также доставка по территории Ярославской области, в такие города как Ярославль, Рыбинск, Тутаев, Переславль-Залесский, Углич, Ростов Великий
А также доставка по территории Ярославской области, в такие города как Ярославль, Рыбинск, Тутаев, Переславль-Залесский, Углич, Ростов Великий
История вопросов по капот на Peugeot 4007:
| Город | Год | Комментарий | |||
|---|---|---|---|---|---|
| Уфа | 2007 | 7901P4, вмятины, царапины | |||
| Красноярск | 2009 | 7901P4, загнут угол, вмятины, царапины | |||
| Челябинск | 2009 | 7901P5, вмятины | |||
| Алматы (KZ) | 2008 | 5900A112, вмятины | |||
| Севастополь | 2011 | 5900A393, вмятины, ржавчина | |||
| Пенза | 2006 | 5900A112, 5900A112, глубокие царапины, сколы краски | |||
| Челябинск | 2006 | 5900A112, 2006, 2.4л, Бензин, Инжектор, 4B12, 5900A112, Джип (5-дверный), черный, сколы, царапины,, царапины | |||
| Кемерово | 2006 | 5900A112, 2006, 2.4л, Бензин, Инжектор, 4B12, 5900A112, Джип (5-дверный), серый, вмятины, царапины,, царапины | |||
| Екатеринбург | 2006 | 5900A220, 2006, 3л, Бензин, Инжектор, 6B31, 5900A220, Джип (5-дверный), царапины, вмятины,загнут угол, | |||
| Красноярск | 2007 | 5900A220, 5900A220, царапины, дефект покрытия | |||
| Красноярск | 2007 | 5900A220, 2007, 3л, Бензин, Инжектор, 5900A220, Джип (5-дверный), серый, вмятины, глубокие царапины, | |||
| Екатеринбург | 2007 | 5900A112, 5900A112, глубокие царапины, мелкие вмятины | |||
| Ханты-Мансийск | 2007 | 5900A220, 2007, 2.4л, Бензин, Инжектор, 4B12, 5900A220, Джип (5-дверный), серебристый, царапины глубокие, вмятины, | |||
| Уфа | 2007 | 5900A220, 2007, 3л, Бензин, Инжектор, 6B31, 5900A220, Джип (5-дверный), серебристый, глубокие царапины, вмятины, ржавчина,, ржавчина | |||
| Владикавказ | 2007 | 5900A112, 2007, 2.4л, Бензин, Инжектор, 5900A112, Джип (5-дверный), синий, глубокие царапины, мелкие вмятины, | |||
| Ярославль | 2007 | 5900A112, 2007, 2л, Дизель, Турбо, BSY, 5900A112, Джип (5-дверный), серый, глубокие царапины, вмятины, ржавчина, | |||
| Казань | 2007 | 5900A112, 2007, 2.4л, Бензин, Инжектор, 5900A112, Джип (5-дверный), серебристый, царапины, мелкие вмятины, загнута кромка, | |||
| Екатеринбург | 2007 | 5900A112, 2007, 2.4л, Бензин, Инжектор, 4B12, 5900A112, Джип (5-дверный), белый, глубокие царапины ,вмятины , сколы краски, | |||
| Ярославль | 2007 | 5900A112, 2007, 2.4л, Бензин, Инжектор, 4B12, 5900A112, Джип (5-дверный), серебристый, глубокие царапины, вмятины,, глубокие царапины, вмятины | |||
| Казань | 2007 | 5900A112, 2007, 2.4л, Бензин, Инжектор, 4B12, 5900A112, Джип (5-дверный), серебристый, царапины,, царапины | |||
| Омск | 2007 | 5900A112, 2007, 2л, Дизель, Турбо, BSY, 5900A112, Джип (5-дверный), серебристый, царапины, вмятины,, царапины, вмятины | |||
| Калининград | 2007 | 5900A112, 2007, 2.4л, Бензин, Инжектор, 4B12, 5900A112, Джип (5-дверный), серый, Фото не актуально, с запчасти отделены: Обшивка капота, царапины, вмятины,, царапины, вмятины | |||
| Екатеринбург | 2011 | капот | |||
| Омск | 2007 | 5900A112, 2007, 2л, Дизель, Турбо, BSY, 5900A112, Джип (5-дверный), серый, +обшивка(порвана), форсунка омывателя 2шт, ржавчина, царапины, вмятины,, ржавчина, царапины, вмятины | |||
| Калининград | 2007 | 5900A112, 2007, 2л, Дизель, Турбо, BSY, 5900A112, Джип (5-дверный), черный, Фото не актуально, с запчасти отделены: Обшивка капота, вмятины, ржавчина, царапины,, вмятины, ржавчина, царапины | |||
| Новосибирск | 2007 | 5900A112, 2007, 2л, Дизель, Турбо, BSY, 5900A112, Джип (5-дверный), серебристый, Фото не актуально, с запчасти отделены: Обшивка капота, залом, ржавчина, глубокие царапины, вмятины,, ржавчина, глубокие царапины, вмятины | |||
| Челябинск | 2007 | 5900A112, 2007, 2л, Дизель, Турбо, BSY, 5900A112, Джип (5-дверный), красный, царапины, вмятины, дефект покрытия (ЛКП),, царапины, вмятины, дефект покрытия (ЛКП) | |||
| Севастополь | 2007 | 5900A112, 2007, 2л, Дизель, 5900A112, Джип (5-дверный), черный, ржавчина, царапины, вмятины, загнут угол (кромка),, ржавчина, царапины, вмятины, загнут угол (кромка) | |||
| Севастополь | 2007 | 5900A220, 2007, 3л, Бензин, Инжектор, 6B31, 5900A220, Джип (5-дверный), серый, ржавчина, царапины, вмятины, порвана обшивка,, ржавчина, царапины, вмятины, порвана обшивка | |||
| Красноярск | 2007 | 5900A112, 2007, 2л, Дизель, Турбо, BSY, 5900A112, Джип (5-дверный), черный, глубокие вмятины, ржавчина, царапины, вмятины, порвана обшивка,, ржавчина, царапины, вмятины, порвана обшивка | |||
| Ростов-на-Дону | 2007 | 5900A112, 2007, 2л, Дизель, BSY, 5900A112, Джип (5-дверный), черный, ржавчина, царапины, вмятины,, ржавчина, царапины, вмятины | |||
| Севастополь | 2007 | 5900A112, 2007, 2л, Дизель, Турбо, BSY, 5900A112, Джип (5-дверный), черный, ржавчина, царапины, вмятины, порвана обшивка,, ржавчина, царапины, вмятины, порвана обшивка | |||
| Алматы (KZ) | 2007 | 5900A112, 2007, 2л, Дизель, Турбо, BSY, 5900A112, Джип (5-дверный), черный, загнут угол, ржавчина, мелкие царапины (вмятины),, загнут угол, ржавчина, мелкие царапины (вмятины) | |||
| Нижний Тагил | 2007 | 5900A112, 2007, 2л, Дизель, Турбо, BSY, 5900A112, Джип (5-дверный), синий, ржавчина, царапины, вмятины, порвана обшивка,, ржавчина, царапины, вмятины, порвана обшивка | |||
| Пенза | 2007 | 5900A112, 2007, 2.4л, Бензин, Инжектор, 4B12, 5900A112, Джип (5-дверный), черный, царапины, вмятины, дефект покрытия (ЛКП),, царапины, вмятины, дефект покрытия (ЛКП) | |||
| Кемерово | 2008 | 5900A220, 2008, 2.4л, Бензин, Инжектор, 5900A220, Джип (5-дверный), серый, царапины глубокие, вмятины, ржавчина,, ржавчина | |||
| Челябинск | 2008 | 5900A393, 2008, 3л, Бензин, Инжектор, 5900A393, Джип (5-дверный), серый, глубокие царапины , вмятины ,, | |||
| Севастополь | 2008 | 5900A112, 2008, 2.4л, Бензин, Инжектор, 4B12, 5900A112, Джип (5-дверный), черный, глубокие царапины, вмятины, загнут угол, загнут клюв в двух местах, | |||
| Уфа | 2008 | 5900A112, 2008, 2.4л, Бензин, Инжектор, 4B12, 5900A112, Джип (5-дверный), черный, Фото не актуально, с запчасти отделены: Обшивка капота, загнут угол, вмятины, глубокие царапины, дефект обшивки, ржавчина,, ржавчина | |||
| Алматы (KZ) | 2008 | 5900A112, 2008, 3л, Бензин, Инжектор, 6B31, 5900A112, Джип (5-дверный), серебристый, загнута кромка, глубокие царапины, вмятины,, глубокие царапины, вмятины | |||
| Нижний Тагил | 2008 | 5900A112, 2008, 2.4л, Бензин, Инжектор, 4B12, 5900A112, Джип (5-дверный), черный, царапины,, царапины | |||
| Пенза | 2008 | 5900A112, 2008, 2л, Дизель, Турбо, BSY, 5900A112, Джип (5-дверный), синий, царапины, ржавчина, | |||
| Ярославль | 2008 | 5900A112, 2008, 2л, Дизель, Турбо, BSY, 5900A112, Джип (5-дверный), серебристый, Фото не актуально, с запчасти отделены: Обшивка капота, загнут угол, мелкие вмятины,, мелкие вмятины | |||
| Красноярск | 2008 | 5900A112, 2008, 2л, Дизель, Турбо, BSY, 5900A112, Джип (5-дверный), серый, Фото не актуально, с запчасти отделены: Обшивка капота, ржавчина, вмятины, царапины,, вмятины, царапины | |||
| Казань | 2008 | 5900A112, 2008, 2л, Дизель, Турбо, BSY, 5900A112, Джип (5-дверный), серебристый, Фото не актуально, с запчасти отделены: Обшивка капота, ржавчина, царапины, вмятины,, ржавчина, царапины, вмятины | |||
| Челябинск | 2008 | 5900A112, 2008, 2.2л, Дизель, 4HN, 5900A112, Джип (5-дверный), черный, Фото не актуально, с запчасти отделены: Обшивка капота, ржавчина, царапины, вмятины, загнут угол (кромка),, ржавчина, царапины, вмятины, загнут угол (кромка) | |||
| Новосибирск | 2008 | 5900A112, 2008, 2л, Дизель, Турбо, BSY, 5900A112, Джип (5-дверный), черный, глубокие царапины, мелкие вмятины, ржавчина,, глубокие царапины, мелкие вмятины, ржавчина | |||
| Ханты-Мансийск | 2008 | 5900A112, 2008, 2л, Дизель, Турбо, BSY, 5900A112, Джип (5-дверный), серебристый, ржавчина, мелкие вмятины, царапины,, ржавчина, мелкие вмятины, царапины | |||
| Пенза | 2008 | 5900A112, 2008, 2.2л, Дизель, Турбо, 4HN, 5900A112, Джип (5-дверный), серый, Фото не актуально, с запчасти отделены: Обшивка капота, загнут угол, ржавчина, царапины, вмятины,, загнут угол, ржавчина, царапины, вмятины | |||
| Алматы (KZ) | 2008 | 5900A112, 2008, 2л, Дизель, Турбо, BSY, 5900A112, Джип (5-дверный), красный, дефект обшивки, ржавчина сквозная, глубокие царапины, вмятины,, ржавчина сквозная, глубокие царапины, вмятины | |||
| Омск | 2008 | 5900A112, 2008, 2л, Дизель, Турбо, BSY, 5900A112, Джип (5-дверный), серый, дефект обшивки, загнут угол, ржавчина, царапины, вмятины,, загнут угол, ржавчина, царапины, вмятины | |||
| Ростов-на-Дону | 2008 | 5900A112, 2008, 2л, Дизель, Турбо, BSY, 5900A112, Джип (5-дверный), серебристый, Фото не актуально, с запчасти отделены: Обшивка капота, ржавчина, царапины, вмятины, загнут угол (кромка),, ржавчина, царапины, вмятины, загнут угол (кромка) | |||
| Омск | 2008 | 5900A112, 2008, 2л, Дизель, Турбо, BSY, 5900A112, Джип (5-дверный), серый, Фото не актуально, с запчасти отделены: Обшивка капота, ржавчина, царапины, вмятины, загнут угол (кромка),, ржавчина, царапины, вмятины, загнут угол (кромка) | |||
| Севастополь | 2008 | 5900A112, 2008, 2л, Дизель, Турбо, BSY, 5900A112, Джип (5-дверный), серый, Дефект обшивки, скол, царапины, вмятины,, скол, царапины, вмятины | |||
| Ханты-Мансийск | 2008 | 5900A112, 2008, 2.2л, Дизель, 4HN, 5900A112, Джип (5-дверный), красный, дефект крепления обшивки капота, ржавчина, царапины, вмятины,, ржавчина, царапины, вмятины | |||
| Челябинск | 2008 | 5900A112, 2008, 2л, Дизель, Турбо, BSY, 5900A112, Джип (5-дверный), черный, ржавчина, царапины, вмятины,, ржавчина, царапины, вмятины | |||
| Пенза | 2008 | 5900A112, 2008, 2л, Дизель, Турбо, BSY, 5900A112, Джип (5-дверный), черный, царапины, вмятины,, царапины, вмятины | |||
| Нижний Тагил | 2008 | 5900A112, 2008, 2л, Дизель, Турбо, BSY, 5900A112, Джип (5-дверный), синий, ржавчина, царапины, вмятины,, ржавчина, царапины, вмятины | |||
| Ярославль | 2008 | 5900A112, 2008, 2л, Дизель, Турбо, BSY, 5900A112, Джип (5-дверный), серебристый, ржавчина, царапины, вмятины,, ржавчина, царапины, вмятины | |||
| Уфа | 2009 | 5900A112, 2009, 2.4л, Бензин, Инжектор, 4B12, 5900A112, Джип (5-дверный), черный, глубокие царапины, вмятины,, глубокие царапины, вмятины | |||
| Уфа | 2009 | 5900A112, 2009, 2.4л, Бензин, Инжектор, 4B12, 5900A112, Джип (5-дверный), серебристый, Фото не актуально, с запчасти отделены: Обшивка капота, загнуты уголы, глубокие царапины, вмятины,, глубокие царапины, вмятины | |||
| Владикавказ | 2009 | 3401A022, 2009, 2.4л, Бензин, Инжектор, 4B12, 3401A022, Джип (5-дверный), серебристый, Фото не актуально, с запчасти отделены: Обшивка капота, глубокие царапины, вмятины,, глубокие царапины, вмятины | |||
| Екатеринбург | 2009 | 5900A112, 2009, 2л, Дизель, Турбо, BSY, 5900A112, Джип (5-дверный), серый, дефект обшивки, вмятины, ржавчина, царапины,, вмятины, ржавчина, царапины | |||
| Казань | 2009 | 5900A112, 2009, 2л, Дизель, Турбо, BSY, 5900A112, Джип (5-дверный), красный, дефект обшивки, ржавчина, царапины, вмятины,, ржавчина, царапины, вмятины | |||
| Ростов-на-Дону | 2009 | 5900A112, 2009, 2.2л, Дизель, Турбо, 4HN, 5900A112, Джип (5-дверный), красный, Фото не актуально, с запчасти отделены: Обшивка капота, ржавчина, царапины, вмятины, дефект покрытия (ЛКП),, ржавчина, царапины, вмятины, дефект покрытия (ЛКП) | |||
| Нижний Тагил | 2009 | 5900A112, 2009, 2л, Дизель, BSY, 5900A112, Джип (5-дверный), серебристый, ржавчина, шпатлевано, царапины, вмятины,, ржавчина, шпатлевано, царапины, вмятины | |||
| Кемерово | 2009 | 5900A112, 2009, 2л, Дизель, Турбо, BSY, 5900A112, Джип (5-дверный), серебристый, ржавчина, царапины, вмятины,, ржавчина, царапины, вмятины | |||
| Казань | 2009 | 5900A112, 2009, 2.4л, Бензин, Инжектор, 4B12, 5900A112, Джип (5-дверный), черный, царапины, вмятины, загнут угол (кромка), порвана обшивка,, царапины, вмятины, загнут угол (кромка), порвана обшивка | |||
| Ханты-Мансийск | 2010 | 5900A393, 2010, 2.3л, Дизель, Турбо, 4N14, 5900A393, Джип (5-дверный), белый, ржавчина, царапины, вмятины,, ржавчина, царапины, вмятины | |||
| Ханты-Мансийск | 2011 | 5900A393, 5900A393, глубокие царапины, вмятины | |||
| Казань | 2012 | 5900A393, 2012, 2.4л, Бензин, Инжектор, 4B12, 5900A393, Джип (5-дверный), темно-синий, Фото не актуально, с запчасти отделены: Обшивка капота, глубокие царапины, вмятины,загнут клюв, загнут угол, | |||
| Севастополь | 2012 | 5900A112, 2012, 2л, Бензин, Инжектор, 4B11, 5900A112, Джип (5-дверный), коричневый, Фото не актуально, с запчасти отделены: Обшивка капота, глубокие царапины, вмятины,, глубокие царапины, вмятины | |||
| Ханты-Мансийск | 2012 | 5900A393, 2012, 2.3л, Дизель, Турбо, 4N14, 5900A393, Джип (5-дверный), черный, примят угол, ржавчина, мелкие вмятины, царапины,, ржавчина, мелкие вмятины, царапины | |||
| Севастополь | 2008 | 7901P4, 2008, 2.2л, Дизель, HDI, 4HN, 7901P4, Джип (5-дверный), черный, царапины, вмятины,, царапины, вмятины | |||
| Калининград | 2009 | 7901P4, 2009, 2.2л, Дизель, HDI, 4HN, 7901P4, Джип (5-дверный), серебристый, ржавчина, царапины, вмятины, загнут угол (кромка), порвана обшивка,, ржавчина, царапины, вмятины, загнут угол (кромка), порвана обшивка | |||
| Пятигорск | 2010 | Только целый | |||
| Иркутск | 2010 | СО ЗНАЧКОМ | |||
| Нижний Новгород | 2011 | нужен б/у капот на Peugeot 4007 2011 г. | |||
Отзывы о компании FINNAUTOPARTS:
В основе философии нашей компании лежит индивидуальный подход к каждому клиенту.
Именно поэтому наши клиенты всегда остаются довольны работой с нами.
Если вам нужны запчасти для а/м Peugeot,
позвоните по телефону +7 499 110-18-75 — наши специалисты подберут
для вас лучший вариант по оптимальной цене.
Все на высшем уровне. Оперативно нашли, быстро доставили. Спасибо.
Заявка #209258
на Peugeot 406
Все супер, работает отлично, молодцы!
Заявка #920629
на Peugeot 206
вышлите док-ты
Заявка #113922
FINNAUTO
Спасибо. Сработали адекватно, правильные, грамотные ответы. Состояние "идеальное" не может соответствовать запчасти Б/у. Мне понравилось.
Заявка #252894
на Peugeot 807
Всё чётко и вовремя
Заявка #707900
на Peugeot 807